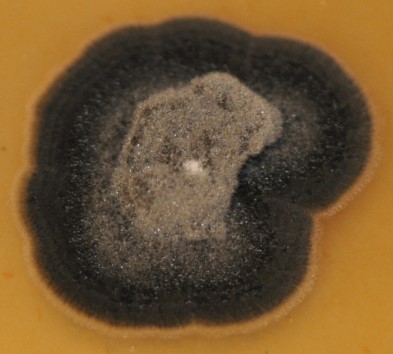

Frogeye Leaf Spot
Cercospora sojina
Hara
Soybean (Glycine max (L.) Merr.)

|
Frogeye leaf spot on soybean, caused by
Cercospora sojina. Courtesy H. Kelly |
Frogeye leaf spot (FLS), caused by the fungal plant pathogen Cercospora sojina Hara, is a common foliar disease of soybean in the United States and other soybean production areas in the world. For many decades, FLS has been prevalent in the southern U.S. and, more recently, has become endemic throughout the Midwest and upper Midwest. Significant yield losses of soybean (10–60%) from this disease have occurred and severity has increased in the last five years due to continued cropping of susceptible soybean varieties over large acreage. Frogeye leaf spot is most likely to become a problem in fields planted with seed infested with the fungus or where residual inoculum from previous soybean crops is present. Extended periods of warm, wet weather during the growing season favor disease development.
Symptoms and Signs
Symptoms of FLS are most visible and typically seen on leaves, but may also occur on stems, pods, and seeds late in the growing season with prolonged conditions that favor disease development (warm and humid conditions). Infection can occur at any stage of soybean development, but most often occurs during reproductive growth stages (from bloom to maturity) and may develop sooner in continuous soybean fields and/or under optimal environmental conditions. The pathogen readily infects young, developing foliage as leaflets are expanding.
Lesions on leaves begin as small, gray, water-soaked spots and develop into gray to brown spots surrounded by narrow, dark reddish-brown margins (Figure 1). These spots are circular to angular in shape and vary in size from less than 1 to 5 mm in diameter. As lesions age, the central areas become ash gray to light brown with thin, reddish-brown margins. On the underside of leaves (Figure 2), the spots are darker and have light- to dark-gray centers.
When sporulating, clusters of conidiophores can be seen in the center of the lesion (Figure 3,
magnified 20X).
In severely infected plants, lesions may coalesce to form larger irregularly shaped spots. When leaves are heavy infected (>30% severity), they may blight and wither quickly before falling prematurely, which may result in significant yield losses.

Figure 1. Lesions, caused by
Cercospora sojina,
on the upper surface of a soybean leaf.
Courtesy H. Kelly |

Figure 2. Lesions, caused by Cercospora sojina, on the underside of a soybean leaf. Courtesy H. Kelly |
|

Figure 3. Sporulation of
Cercospora sojina visible
in the center of a lesion on the underside of a leaf.
Courtesy H. Kelly |
Pathogen Biology
Cercospora sojina is
a close relative of the fungus that causes Cercospora leaf spot and purple seed stain (Cercospora kukuchii) in soybean.
C. sojina is highly variable in colony color, rate of growth, and sporulation on culture media (Figure 4). Conidia are produced on light to dark brown conidiophores borne in fascicles arising from a thin stroma formed on infected leaves, stems or seeds, or infested crop residue. Conidia form on tips of conidiophores (Figure 5) and are pushed aside as the conidiophores continue to grow. Conidia are hyaline, and cylindrical to fusiform, tapering toward the tip, and 6 to 8 µm by 40 to 70 µm in size with up to 10 septa (Figure 6). The size and shape of conidia and conidiophores vary with the substrate on which the fungus grows. During the growing season, conidia of
C. sojina serve as the primary and secondary inocula for FLS infections. If conidia land on susceptible tissue, they can initiate infection
resulting in development of visible lesions within 8 to 12 days.
Figure 4.
Sporulation of
Cercospora
sojina on V8 culture media.
Courtesy B. Lin | 
Figure 5.
Conidia of
Cercospora sojina
form on tips of conidiophores.
Courtesy B. Lin |

Figure 6. Conidia of
Cercospora sojina are
elongate to fusiform, tapering toward the tip,
with up to 10 septa. Courtesy of B. Lin
|
According to the current published research, it is debatable if
C. sojina can produce cercosporin in-planta, although it does not produce cercosporin in culture. Cercosporin is a photosensitizer (photoactivated and lacks toxicity in the dark), which has been shown to play an important role in
Cercospora diseases of diverse hosts. Its toxicity is due to oxidative damage to lipids, proteins, and nucleic acids of cell membranes and it is a potent producer of singlet oxygen. Although this compound may enhance virulence, it is not a universal pathogenicity factor because it is not produced by all
Cercospora species. The ability to produce cercosporin is often specific to strains or isolates, and is influenced by various environmental and nutritional conditions.
Cercospora sojina is a dynamic pathogen with extensive virulence or race diversity. Sets of soybean differential cultivars have been used to identify C. sojina races, which provides the foundation for the identification and comparison of additional soybean resistance genes and new races of
C. sojina. Between 12 and 20 distinct physiological races are thought to exist in the U.S. and have been reported from several states. Various sets of differential hosts have been used to separate these races which makes determining similarity of races difficult.
Disease Cycle and Epidemiology
“Disease cycle”. Disease cycle of frogeye leaf spot, caused by
Cercospora sojina. Courtesy A. Grahek
Frogeye leaf spot is a polycyclic disease in which infection, symptom development, and production of conidia are repeated throughout the growing season. The amount of disease is influenced by the primary or first inoculum (the amount of initial inoculum) and the number of disease cycles that occurs in the field.
Cercospora sojina overwinters as mycelium in infected seeds and infected soybean residue. Initial infection occurs as conidia produced on infected residues or cotyledons are dispersed by splashing rain or wind. Dew and rain events produce favorable environmental conditions to promote secondary infections as conidia are dispersed to other areas on the plant or are carried in rain and wind to surrounding fields. Warm (25-30°C) and wet weather (e.g. rain, heavy dew or >90% relative humidity) conditions favor infection and disease development. Following infection, lesions are visible after 7 to 14 days depending on the conditions. Leaves are most susceptible to infection as they are emerging and become less susceptible as they mature. Mild winter temperatures and conservation tillage favor pathogen survival. Diseased soybean residue (leaves, stems and pods) left on the soil surface provides inoculum to continue disease cycle in next soybean crop. If the first symptoms of this disease are detected late in the season (at or after growth stage R5/beginning seed) there is very little impact on the plant. However, if this cycle begins prior to or at flowering, then substantial amounts of disease can develop that will impact yield. Under conducive conditions, the fungus will continue to produce conidia and secondary infections, which increases disease severity.
Disease Management of Frogeye Leaf Spot
Cultural Practices
The frogeye pathogen survives winters in infested soybean residue. Therefore, crop rotation and tillage can be effective means of reducing the population from season to season. Two-year rotations with crops other than soybean may help to reduce the level of
C. sojina inoculum. Previous research indicated that tillage alone did not significantly reduce disease severity, but tillage resulted in increased fungicide efficacy when compared to fungicide treatment in no-till cultivation in side-by-side, small plot field trials. The possible explanation for similar disease severity in tilled and no-till plots is that inoculum from other sources, such as bordering rows, neighboring fields, and inoculum from possible weedy hosts could be influencing FLS development and severity. Planting clean, pathogen-free seed is also recommended to prevent introduction of primary inoculum into the field. The relative contribution of primary inoculum in infected seed versus crop residue is not clear. Based on current production practices, it is believed that residue may be a more significant source of inoculum than infected seed, but infected seed may establish the fungus in new areas.
Resistant Varieties
Host resistance is the most effective and economical management practice for frogeye leaf spot. Several different genes for frogeye leaf spot resistance have been discovered and described in soybean. Currently,
Rcs1,
Rcs2, and
Rcs3 are three named genes by the Soybean Genetics Committee for frogeye leaf spot resistance, and additional sources of resistance have been reported. There are several races of the pathogen, which are distinguished by their ability to infect soybean varieties with different genes for resistance. A soybean variety with one particular gene for resistance will be resistant to some races of the pathogen, but not others. The
Rcs3 gene is known to confer resistance to all known races that occur in the U.S.
Chemical Control
Foliar applications of fungicides can be effective in managing diseases and are most effective when applied preventatively to protect new growth when conditions favor disease development. Research from multiple states in the U.S. has indicated that applications made between R2 and R5 soybean growth stages (full bloom to beginning seed) are the most economical for control of FLS. Most fungicide applications made with the label rate will provide some residual activity for between 14 and 21 days depending on the products applied, water volume of application (coverage), and environmental conditions after application. Additionally, fungicide applications coupled with tillage practices may assist in reducing FLS severity and increase yield. Fungicides belonging to the quinone outside inhibitor (QoI) group (FRAC group 11) had been effective in managing frogeye leaf spot, but
C. sojina isolates that have developed resistance to the QoI fungicide group
have been observed in 13 states (AL, AR, DE, IL, IN, KY, LA, MO, MS, NC, OH, TN, and VA).
Significance
Since 1999, increased severity and prevalence of FLS have been reported in some southern and north central areas of the U. S. Outside the U. S.,
C. sojina has been reported in at least 27 countries spanning North and South America, Europe, Africa, and Asia. Warmer winter temperatures, susceptible soybean germplasm, and conservation tillage practices have been proposed as potential causes for recent outbreaks of FLS. In the U.S., yield loss caused by frogeye leaf spot on susceptible soybean cultivars have been reported as high as 60% due to the result of reduction in photosynthetic area, premature defoliation, and the reduction of seed quality. Estimated annual soybean yield losses (bushels, in thousands) caused by FLS in the United States ranged between 3,727 and 18,147 from 2010 to 2014. Since the first report of QoI-fungicide-resistant isolates of
C. sojina in the U.S., the number of reports and amount of QoI resistance in
C. sojina has increased. QoI-resistant
C. sojina has been reported in 13 states (AL, AR, DE, IL, IN, KY, LA, MO, MS, NC, OH, TN, and VA) as of year-end 2016. Without alternative fungicides that are effective at managing QoI-resistant
C. sojina and other integrated pest management strategies, the QoI-resistant frogeye leaf spot could have caused significant losses to U.S. farmers.
Selected References
Akem, C. N., and Dashiell, K. E. 1994. Effect of planting date on severity of frogeye leaf spot and grain yield of soybeans. Crop Protection 13:607-610.
Athow, K. L, Probst, A. H., Kartzman, C. P., and Laviolette, F.A. 1962. A newly identified physiological race of
Cercospora sojina on soybean. Phytopathology. 52:712-714.
Bradley, C. A., Wood, A., Zhang, G. R., Murray, J. E., Phillips, D. V., and Ming, R. 2012. Genetic diversity of
Cercospora sojina revealed by amplified fragment length polymorphism markers. Can. J. Plant Pathol. 34:410-416.
Crous, P.W., and Braun, U. 2003.
Mycosphaerella and its anamorphs: 1. Names published in
Cercospora and
Passalora. Centraalbureau voor Schimmelcultures, Utrecht.
Cruz, C. D., and Dorrance, A. E. 2009. Characterization and survival of
Cercospora sojina in Ohio. Online. Plant Health Progress, doi:10.1094/PHP-2009-0512-03-RS.
Grau, C. R., Dorrance, A. E., Bond, J., and Russin, J. S. 2004. Fungal diseases. Pages 732-734 in: Soybeans: Improvement, Production, and Uses, 3rd Ed. H. R. Boerma and J. E. Specht, eds. Monogr. 16. Am. Soc. of Agron., Madison, WI.
Khan, J., del Rio, L. E., Nelson, R., Rivera-Varas, V., Secor, G. A., and Khan, M. F. R. 2008. Survival, dispersal, and primary infection site for
Cercospora beticola in sugar beet. Plant Dis. 92:741-745.
Ma, S. M., and Li, B. 1987.
Cercospora sojina overwinter test. Soybean Sci. 25:29-34.
Melchers, L. E. 1925. Diseases of cereal and forage crops in the United States in 1924. Plant Dis. Rep. (Suppl.) 40:186.
Mengistu, A., Kelly, M. H., Bellaloui, N., Arelli, R. P., Reddy, N. K., and Wrather, J. A. 2014. Tillage, fungicide and cultivar effects on frogeye leaf spot severity and yield in soybean. Plant Dis. 98:1476-1484.
Mian, M. A. R., Missaoui, A. M., Walker, D. R., Phillips, D. V., and Boerma, H. R. 2008. Frogeye leaf spot of soybean: A review and proposed race designations for isolates of
Cercospora sojina Hara. Crop Science. 48:14-24.
Wrather, A., Shannon, G., Balardin, R., Carregal, L., Escobar, R., Gupta, G. K., Ma, Z., Morel, W., Ploper, D., and Tenuta, A. 2010. Effect of diseases on soybean yield in the top eight producing countries in 2006. Online. Plant Health Progress doi:10.1094/PHP-2010-0125-01-RS.
Zeng, F., Zhang, G., Olaya, G., Wullschleger, J., Sierotzki, H., Ming, R., and Bradley, C. 2015.
Characterization of quinone outside inhibitor fungicide resistance in Cercospora sojina and development of diagnostic tools for its identification. Plant Disease.
99:544-550.
Zhang, G. R., Newman, M. A., and Bradley, C. A. 2012. First report of the soybean Frogeye leaf spot fungus (Cercospora sojina) resistant to quinone outside inhibitor fungicides in North America. Plant Disease. 96:767-767.
